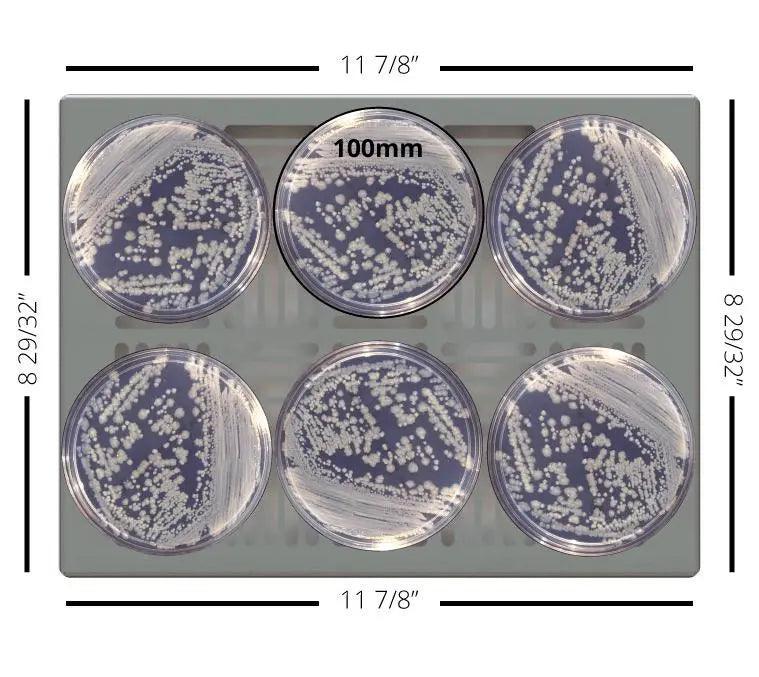

Refurbished USA Incubators
SKUiCL-020L-D071-REFURB
Product Overview
The digitally controlled USA Incubators from LW Scientific are perfect for various applications such as cultures, egg incubation, test kits, and other microbiological uses in pediatric, physician, and hospital labs. This new line of incubators is designed, engineered, and assembled in the USA by LW Scientific Atlanta. They provide better temperature stability and accuracy with the digital PID microprocessor controls, and the convection heat provides excellent heat distribution and uniformity. The LED temperature display shows constant temperature in Celsius or Fahrenheit, and the aluminum and stainless steel components are corrosion resistant and easy to clean.
The LW Scientific Incubator is perfect for labs requiring better temperature accuracy and a small footprint.
Support & Resources
Support & Resources
Couldn't load pickup availability

Refurbished USA Incubators
Recently Viewed

Subscribe to our emails